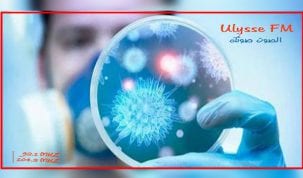

التصنيف: جهوية

تطاوين : شلل اٍداري منذ أيام و تجاهل حكومي للأوضاع في الجهة
عبر أهالي ولاية تطاوين عن استغرابهم من عدم تفاعل الحكومة مع الأحداث الواقعة بالجهة مؤخرا بعد 4 أيام من

ولاية مدنين تستقبل 1682 مواطنا عائدين من الخارج
استقبلت ولاية مدنين يوم أمس، 1682 مواطنا عائدين من الخارج مقسمين بين 1371 مواطنا قادمين من فرنسا على متن

جربة / آجيم : يوم اٍعلامي حول الاٍستثمار والاٍمتياز في القطاع الفلاحي
ينظم الاتحاد المحلي للفلاحة والصيد البحري بجربة آجيم بالتنسيق مع خلية الارشاد الفلاحي باجيم ومركز التكوين المهني الفلاحي بالفجاء

مدنين: الهيئة الفرعية للانتحابات تعلن عن صرف منحة أعضاء مكاتب اقتراع
اعلنت الهيئة الفرعية للانتخابات بمدنين عن صرف منحة أعضاء مكاتب اقتراع تخص الذين لم تصرف لهم سابقا لتسرب خطأ

جربة : غدا حملة التقصي العشوائي لفيروس كورونا تحت اٍشراف وزير الصحة
أكد الدكتور زيد العنز كاهية مدير الصحة الاساسية للصحة بالادارة الجهوية للصحة بمدنين أن حملة التقصي العشوائي ل3000 عينة

بنقردان : فرقة الأبحاث العدلية للحرس الوطني تؤكد أن الجثة التي تم العثورعليها هي لمواطن تونسي
بعد عثور فرقة الأبحاث العدلية للحرس الوطني بنقردان على جثة مجهولة الهوية تحمل أثار عنف أمس على مستوي الطريق

الاٍدارة الجهوية للصحة بمدنين تؤكد اٍستقرار الوضع الصحي بالولاية
تلقت الاٍدارة الجهوية للصحة بمدنين مساء امس، نتائج 25 عينة تم رفعها للتحليل لتقصي فيروس كورونا، من بينها عينات

المهدية : 7 إصابات جديدة بكورونا لدى طلبة وافدين من روسيا
أعلنت الاحد الإدارة الجهوية للصحة بالمهدية عن تسجيل 7 إصابات جديدة بكورونا لدى طلبة وافدين من روسيا، جميعهم غير

روني الطرابلسي وزير السياحة والصناعات التقليدية السابق يغادر قسم الإنعاش باحدى المصحات الخاصة بباريس .
غادر روني الطرابلسي وزير السياحة والصناعات السابق مطلع الأسبوع الحالي قسم الإنعاش باحدى المصحات الخاصة بباريس أين كان يخضع
مدنين: 5 اصابات جديدة بفيروس كورونا المستجد كلها وافدة من المملكة العربية السعودية
سجلت مساء اليوم الادارة الجهوية للصحة بمدنين 5 حالات اصابة جديدة بفيروس كورونا المستجد كلها لوافدين من المملكة العربية

